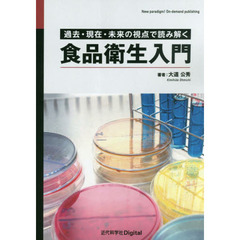
食品衛生入門　過去・現在・未来の視点で読み解く

食品学
条件を絞り込んで探す
- 日本フードスペシャリスト協会/編 (34)
- 家庭栄養研究会 (33)
- FLAネットワーク協会/編 (21)
- 家庭栄養研究会 編集 (19)
- 食品衛生研究会/編集 (17)
- 日本給食指導協会/編 (14)
- 木村 修一 他編 (14)
- 実教出版編修部/著 (13)
- 吉田勉/監修 (12)
- 日本輸入食品安全推進協会/編著 (11)
- 日本食品添加物協会技術委員会/編 (11)
- 村井美月/著 (10)
- 西田博/著 (10)
- 谷口亜樹子/編著 (10)
- 高橋敦子/編 安原安代/編 松田康子/編 (9)
- 内藤茂三/著 (8)
- 高橋正郎/監修 (8)
- 高部和子/〔ほか〕編集 (8)
- 中山正夫/著 (7)
- 増尾清/著 (7)
- 廣末トシ子/編 安達修一/編 (7)
- 江原絢子/編・解説 (7)
- 竹森美佐子/監修・著 (7)
- 細貝祐太郎/監修 松本昌雄/監修 (7)
- ユーキャン食生活アドバイザー検定試験研究会/編 (6)
- 一色賢司/編 (6)
- 仲尾玲子/著 中川裕子/著 (6)
- 吉田菊次郎/著 (6)
- 宮澤陽夫/監修 (6)
- 山本祥一朗/著 (6)
- 給食管理教育問題研究 (6)
- 藤田哲/著 (6)
- 食品衛生研究会 編集 (6)
- 食品衛生研究会/監修 (6)
- フルネット出版編集部/編集 (5)
- 久保田紀久枝/編 森光康次郎/編 (5)
- 北本勝ひこ/監修 (5)
- 多仁照広/編 (5)
- 太田静行/著 (5)
- 山崎春栄/著 (5)
- 山野善正/監修 (5)
- 日本福祉大学知多半島総合研究所/共編著 博物館「酢の里」/共編著 (5)
- 早川幸男/著 (5)
- 東和男/編著 (5)
- 清水俊雄/著 (5)
- 渡辺雄二/著 (5)
- 玉川和子/著 口羽章子/著 木地明子/著 (5)
- 篠田次郎/著 (5)
- 細貝祐太郎/編 松本昌雄/編 廣末トシ子/編 (5)
- 菅家祐輔/編著 (5)
- 藤井建夫/著 塩見一雄/著 (5)
- 食品工業編集部/編纂 (5)
- 香西みどり/編著 綾部園子/編著 (5)
- 主婦と生活社/編 (4)
- 井土貴司/著 (4)
- 吉田照男/著 (4)
- 天笠啓祐/著 (4)
- 寺尾純二/共著 山西倫太郎/共著 高村仁知/共著 (4)
- 小若順一/著 (4)
- 山本哲郎/監修 (4)
- 川端 晶子 著 大羽 和子 著 (4)
- 日本食品工業学会/編 (4)
- 日本食品科学工学会/編 (4)
- 桜木廂夫/著 (4)
- 森田潤司/編 成田宏史/編 (4)
- 秋山裕一/共著 原昌道/共著 (4)
- 細貝祐太郎/編 松本昌雄/編 影井昇/〔ほか〕著 (4)
- 総合食品研究所/編集 (4)
- 藤原邦達/著 (4)
- 西堀すき江/編著 安藤京子/〔ほか〕共著 (4)
- 講談社/編 (4)
- 郡司和夫/著 (4)
- 露木英男/編著 田島真/編著 (4)
- 食品表示研究会/編集 (4)
- 食料・農業政策研究センター/編集 (4)
- 高城孝助/編著 三好恵子/編著 松月弘恵/編著 (4)
- 高橋清隆/著 (4)
- 高瀬斉/著 (4)
- Kenneth F.Kiple/〔編〕 Kriemhild Conee Ornelas/〔編〕 石毛直道/〔ほか〕シリーズ監訳 (4)
- 『サライ』編集部/編 本多由紀子/編 (3)
- イヴ・チュリエ/〔著〕 千石玲子/訳 千石禎子/訳 (3)
- ニューフード・クリエーション技術研究組合/編 (3)
- 今井忠平/著 (3)
- 佐々木久子/著 (3)
- 動物性食品のHACCP研究班/編集 (3)
- 厚生省生活衛生局食品 (3)
- 厚生省食品衛生課/〔ほか〕共編 (3)
- 古川秀子/編著 上田玲子/共著 (3)
- 吉田勉/監修 早瀬文孝/編著 佐藤隆一郎/編著 臼井照幸/〔ほか〕共著 (3)
- 吉田勉/編著 篠田粧子/〔ほか〕著 (3)
- 大越ひろ/編著 品川弘子/編著 飯田文子/編著 (3)
- 太田明一/監修 (3)
- 太田静行/〔ほか〕著 (3)
- 小川正/編集 的場輝佳/編集 (3)
- 小沢国男/著 (3)
- 山田博士/著 (3)
- 岡庭昇/著 (3)
- 岡本裕子/編集 加藤由美子/編集 君羅満/編集 秋山聡子/〔ほか〕執筆 (3)
- 新調理研究会/編 (3)
- 新調理研究会/編 オーム社開発局/企画編集 (3)
著者
- 建帛社 (185)
- 日本食糧新聞社 (131)
- 朝倉書店 (114)
- 中央法規出版 (107)
- 幸書房 (103)
- シーエムシー出版 (100)
- 三共出版 (95)
- 食品化学新聞社 (94)
- 光琳 (91)
- 講談社 (88)
- 日本食品衛生協会 (70)
- 医歯薬出版 (61)
- 第一出版 (61)
- 光生館 (59)
- 同文書院 (58)
- 食べもの通信社 (55)
- 化学同人 (46)
- 新日本法規出版 (42)
- 学文社 (39)
- 学建書院 (38)
- 食品産業新聞社 (38)
- 恒星社厚生閣 (36)
- 南江堂 (35)
- 実教出版 (33)
- 食品産業センター (32)
- アイ・ケイコーポレーション (30)
- 東京化学同人 (23)
- 流通システム研究センター (23)
- エヌ・ティー・エス (22)
- 日本能率協会マネジメントセンター (21)
- 女子栄養大学出版部 (20)
- 農山漁村文化協会 (20)
- 共立出版 (19)
- 日本経済新聞出版社 (19)
- 東京教学社 (19)
- 貿易日日通信社 (18)
- 全国学校給食協会 (17)
- 日本食品添加物協会 (15)
- 樹村房 (15)
- 食品研究社 (15)
- フルネット (14)
- 培風館 (14)
- 柴田書店 (14)
- 農林統計協会 (14)
- 丸善 (13)
- 日刊工業新聞社 (13)
- 理工学社 (13)
- 地人書館 (12)
- 技報堂出版 (12)
- オーム社 (11)
- シーエムシー (11)
- 合同出版 (11)
- 秀和システム新社 (11)
- サイエンスフォ (10)
- 学会出版センター (10)
- 食品需給研究センター (10)
- 二期出版 (9)
- 平凡社 (9)
- 日本食品添加物 (9)
- 理工図書 (9)
- 筑波書房 (9)
- 裳華房 (9)
- 鎌倉書房 (9)
- さんえい出版 (8)
- ダイヤモンド社 (8)
- ポプラ社 (8)
- 主婦と生活社 (8)
- 地球社 (8)
- 小学館 (8)
- 弘学出版 (8)
- 時事通信社 (8)
- 東洋経済新報社 (8)
- 芽ばえ社 (8)
- クレス出版 (7)
- ナツメ社 (7)
- パンニュース社 (7)
- 三一書房 (7)
- 中央公論社 (7)
- 成山堂書店 (7)
- 日本経済評論社 (7)
- 日科技連出版社 (7)
- 玉光堂 (7)
- 読売新聞社 (7)
- ぎょうせい (6)
- ユーキャン学び出版 (6)
- 一橋出版 (6)
- 三水社 (6)
- 丸善出版 (6)
- 健友館 (6)
- 家の光協会 (6)
- 工業調査会 (6)
- 放送大学教育振興会 (6)
- 日報出版 (6)
- 明文書房 (6)
- 産業調査会 (6)
- 葦書房 (6)
- 農経新聞社 (6)
- 霞出版社 (6)
- 食品流通研究会 (6)
- 養賢堂 (6)
出版社
中嶋加代子/編著 山田志麻/編著 数野千恵子/著 冨永美穂子/著 岸本律子/著 澤田崇子/著 廣田幸・・・ (本・コミック)
販売価格: 2,400円 (税込2,640円)
12 ポイント
![]()
解説食品トレーサビリティ ガイドラインの考え方/コード体系、ユビキタス、国際動向/導入事例 ガイドライン改訂第2版対応版
新山陽子/編 坂本尚登/〔ほか執筆〕 (本・コミック)
販売価格: 2,400円 (税込2,640円)
12 ポイント
![]()
スタンダード食品学 管理栄養士・栄養士のためのフードリテラシー 改訂新版
五明紀春/共著 三浦理代/共著 田島眞/共著 (本・コミック)
販売価格: 2,900円 (税込3,190円)
14 ポイント
![]()
山崎清子/共著 島田キミエ/共著 渋川祥子/共著 下村道子/共著 市川朝子/共著 杉山久仁子/共著 ・・・ (本・コミック)
販売価格: 2,800円 (税込3,080円)
14 ポイント
![]()
賞味期限設定・延長のための各試験・評価法ノウハウ 保存試験・加速〈虐待〉試験・官能評価試験と開発成功事例
山崎勝利/著 朝田仁/著 (本・コミック)
販売価格: 32,000円 (税込35,200円)
160 ポイント
![]()
佐竹元吉/著 正山征洋/著 和仁皓明/著 医療経済研究・社会保険福祉協会/編集企画 (本・コミック)
販売価格: 1,800円 (税込1,980円)
9 ポイント
![]()